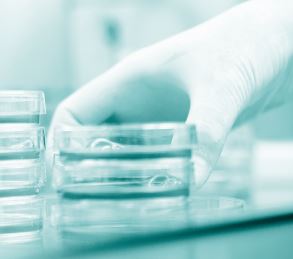

Beskrivelse
En struktureret overflade forbedrer skridsikkerheden og giver et sikkert greb.
Disse handsker er fremstillet af nitril og har en overlegen punkteringsmodstand
sammenlignet med almindelige latexversioner samt en forbedret
modstandsdygtighed over for kemikalier.
Nitrilens lette og elastiske natur giver en fremragende
følesans og en behagelig bæreoplevelse, selv når den bæres
i lange perioder.
Holdbart manchetdesign med perler gør det muligt at tage handsken på effektivt,
og hjælper den med at forblive sikkert på plads, når den bæres.
Behandlet i et renrumsmiljø for at sikre kompatibilitet med
ISO klasse 5 driftsbetingelser.
Minimerer de potentielle konsekvenser af pudderbåren dermatitis, og
kan bæres af personer med type I-latexfølsomhed.
– Pulverfri
– Manchet med perler
– ESD-egenskaber

-Nitrilhandskar/PRIME-Glove-Plus-Prime-Black-Nitrilhandskar-1-180x180.jpg)







